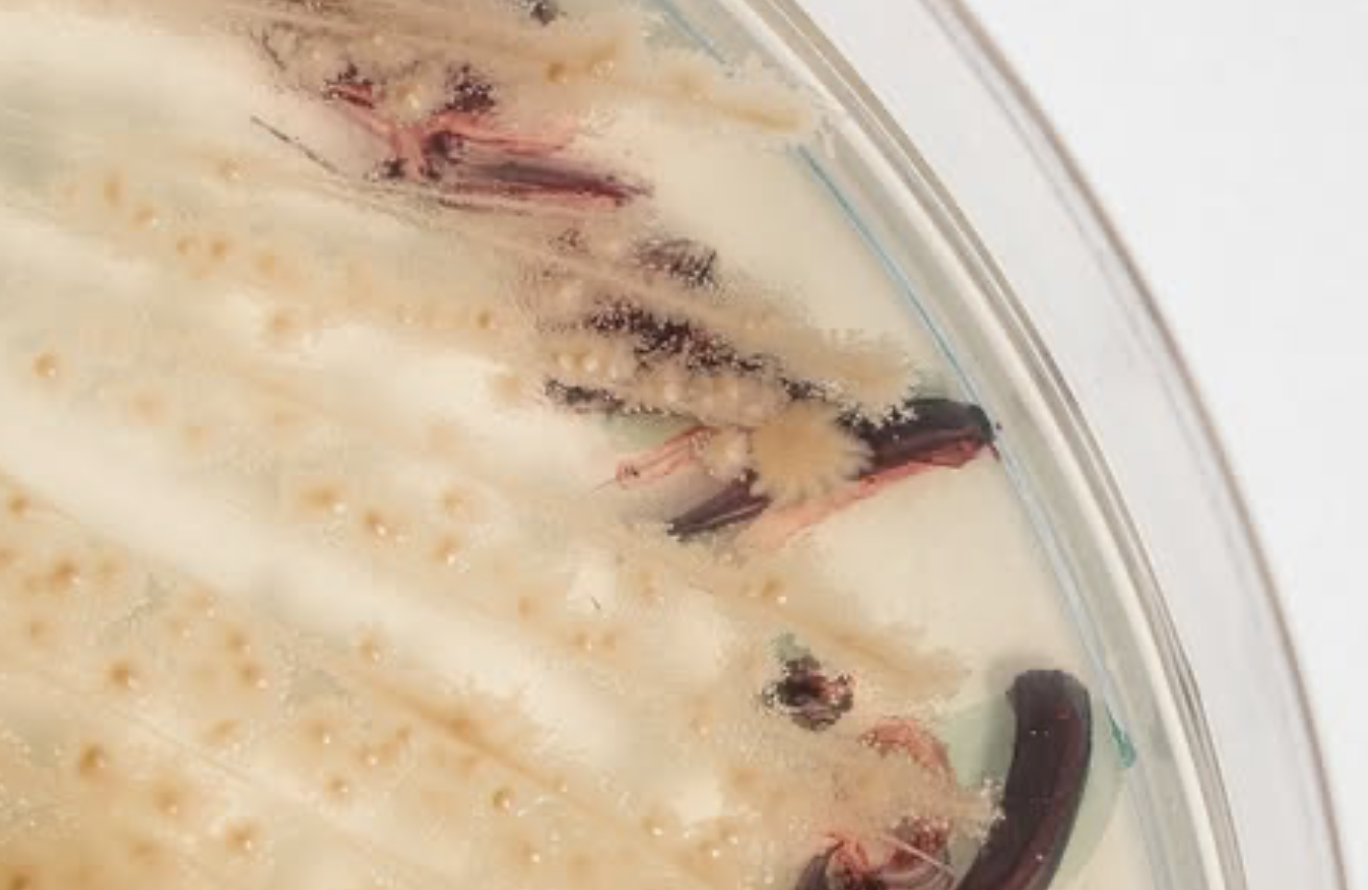

Somewhere in a lab, a machine is printing muscle. Or bone. Or a biohybrid scaffold that looks suspiciously like coral—but isn’t. It might heal. It might grow. It might decay. It’s not a product. It’s not quite alive. But it could be. The strange frontier of 3D bioprinting and organic fabrication, where biology is no longer grown but designed—layer by microscopic layer.
Once relegated to the outer edges of speculative design and sci-fi medicine, bioprinting is rapidly becoming a core tool in fields ranging from regenerative healthcare to sustainable architecture to experimental fashion. Like any powerful technology on the rise, it’s raising big questions about the boundaries of life, the ethics of creation, and the aesthetics of engineered nature.
In short: We’re not just printing things. We’re printing living things. And that changes everything.

The Basics: What Exactly Is Bioprinting?
At its core, 3D bioprinting is the process of creating structures composed of biological materials—cells, proteins, hydrogels, and sometimes synthetic scaffolds—by layering them using a modified 3D printer. Think of it as the lovechild of inkjet printing and tissue engineering.
Instead of extruding molten plastic, these machines print with bioinks—composite materials designed to support cell viability and function. After printing, the structures are often incubated, grown, or integrated into living systems.
Some use cases are highly medical: lab-grown cartilage for reconstructive surgery, vascular tissue for transplant trials, or skin grafts that match a patient’s cellular signature. But others are more conceptual—and occasionally controversial. Bioprinted art. Living architecture. Clothing made from printed microbial leather. Even speculative menus featuring lab-grown, 3D-printed sushi.
The line between biology and design is no longer blurry. It’s programmable.
Printing Organs (and Expectations)
Let’s get one thing out of the way: we’re not printing fully functional human hearts yet. Despite the headlines, printing complex, vascularized organs that function like the originals is still years—possibly decades—away. But we’re getting closer.
In the Netherlands, Utrecht University Hospital has used bioprinted bone structures in jaw reconstructions. Startups like Trestle Biotherapeutics and CELLINK are working on printable kidney tissue and functional liver patches. In 2024, scientists from Harvard’s Wyss Institute developed an 'ink' that prints tissue capable of withstanding mechanical stress—essential for muscle and tendon repair.

The promise? Personalized regenerative medicine—printing tissues using a patient’s own cells, reducing the risk of rejection, and maybe one day, eliminating the need for donor organs entirely.
The challenge? Biology is messy. It doesn’t like being told what shape to take. And printing something that stays alive, functions, and integrates with the body is an engineering nightmare—equal parts chemistry, code, and luck.
Beyond the Clinic: Fabrication as Ecosystem
But bioprinting isn’t just about medicine. Designers and architects are pushing the technology into new, weird terrain.
Faber Futures, a London-based design studio founded by Natsai Audrey Chieza, explores the potential of biotechnology in creating sustainable materials and systems. One of her notable projects, Project Coelicolor, involves using the bacterium Streptomyces coelicolor to dye textiles, offering a natural and sustainable alternative to synthetic dyes. This innovative approach not only reduces environmental impact but also opens new avenues for biofabrication in the fashion industry.

In Copenhagen, the Living Architecture (LIAR) project, active from 2016 to 2019, developed modular, 3D-printed structures—referred to as "living bricks"—that incorporated microbial fuel cells and biofilms. These components proposed solutions and structures to process waste, generate electricity, and interact with their environment, effectively transforming building elements into metabolically active systems.


Meanwhile, designers at Modern Synthesis, a London-based biotech company founded by Jen Keane and Dr. Ben Reeve, are using bacterial nanocellulose to create high-performance, biodegradable textiles. Their process cultivates microbes that transform agricultural waste into customizable, non-petrochemical fibers compatible with traditional manufacturing.
This isn’t just greenwashing. It’s a radical rethink of what materials do. The new goal isn’t durability—it’s responsiveness. Self-repair. Decomposition. Regeneration. A living wall might change color based on pollution levels. A wearable might adapt to your body’s temperature and hydration in real time. And yes, eventually compost itself.
In this framework, fabrication becomes ecological. Biology becomes infrastructure. Buildings breathe. Shirts grow. Objects die with dignity.
The Art of the Organic
Naturally, artists are already playing with this toolkit. Maurizio Montalti, an Italian designer, researcher, and founder of Officina Corpuscoli based in the Netherlands explores the intersection of design and biotechnology, challenging cultural stigmas and notions of material permanence. His practice is grounded in transdisciplinary research and a fascination with the micro-scale as a lens for reimagining our macro-world. Interrogating the boundaries between human and non-human, his work invites more symbiotic relationships within a living, responsive ecosystem.
Amy Karle, whose speculative bioprinted bone structures blend bioethics, spiritual inquiry, and regenerative aesthetics—often displayed in bell jars that nod to 19th-century science and 21st-century sci-fi.
These works don’t just showcase what bioprinters can do. They ask: Should they? Who gets to design life? And what happens when objects stop being “products” and start becoming organisms?
The Future Is Growing (and Glitching)
There’s no doubt: bioprinting is going to reshape the way we build, heal, clothe, and decorate the world. But like any tool born from techno-optimism, it comes with caveats.
What counts as “living”? If a structure made from stem cells functions but can’t reproduce, is it alive? If a building can adapt to its climate but has no DNA, does it count as an organism?
What about failure? When your 3D-printed phone case melts, it’s annoying. When your 3D-printed kidney fails, it’s catastrophic. Designing for organic complexity requires new safety protocols, new ethics, and new humility.
And what’s the endgame? A world where every object is biologically responsive sounds beautiful. But also exhausting. Will your furniture catch moods? Will your walls know your pulse? Is there such a thing as too alive?
Coda: The Printer Is the Planet
Ultimately, the most radical shift bioprinting brings isn’t technological. It’s philosophical.
We’ve spent centuries trying to mechanize the world—to make nature legible, repeatable, industrial. Bioprinting doesn’t reject that logic. But it twists it. Instead of conquering nature, we’re learning to code with it. To collaborate. To scaffold growth rather than force it.
In this future, fabrication isn’t about control. It’s about invitation.
The printer doesn’t make the thing. It starts the thing growing.
And we? We’re no longer manufacturers. We’re gardeners of possibility.










